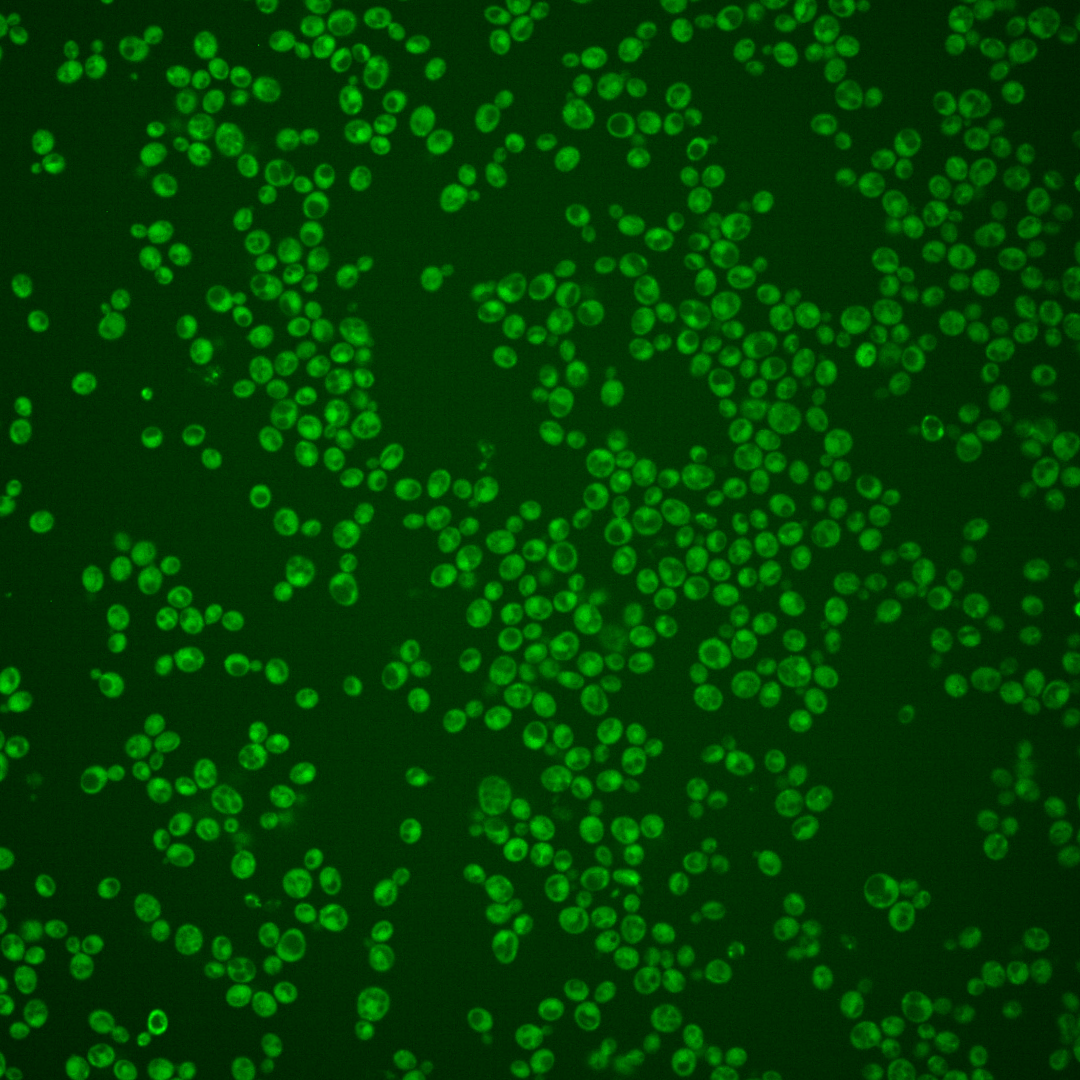
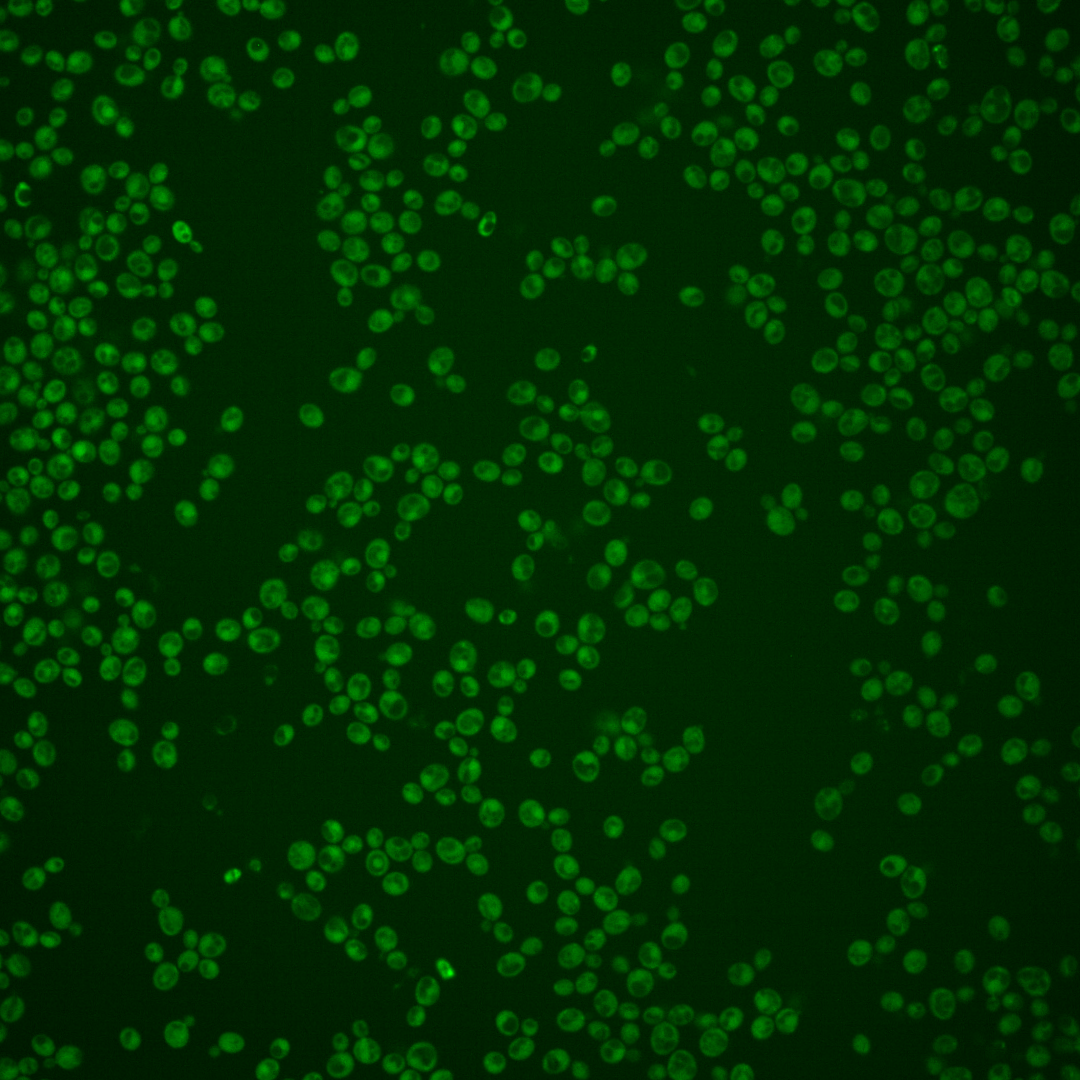
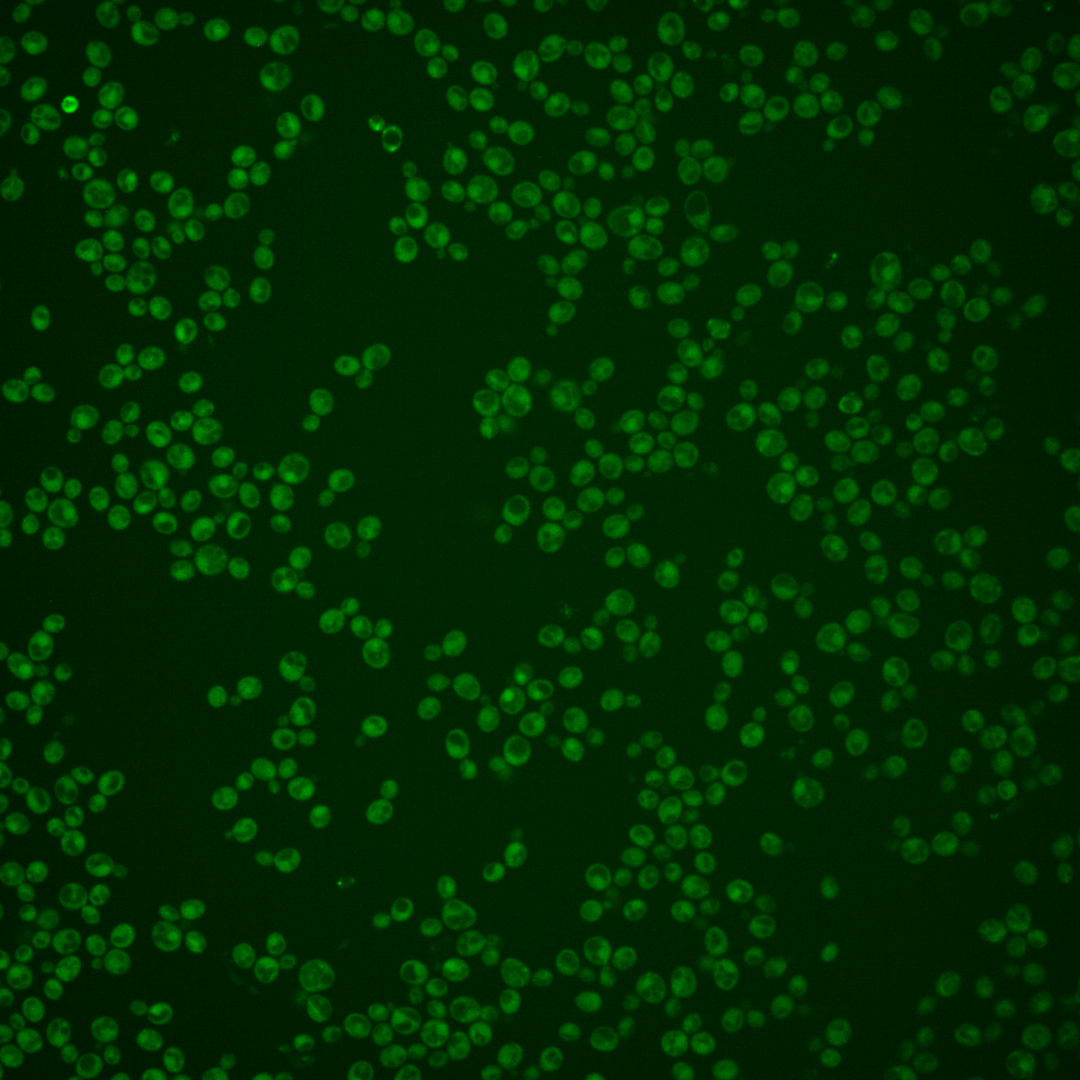

| Standard name | |
|---|---|
| Human Ortholog | |
| Description | Protein that interacts with Rab GTPases; localized to late Golgi vesicles; computational analysis of large-scale protein-protein interaction data suggests a possible role in vesicle-mediated transport |
Micrographs




















































































Sub-cellular Localization
Yeast GFP Assignment
Protein Abundance
Localization Change
External localization resources
| ensLOC | DeepLoc | |||||||||||||||||||||||
|---|---|---|---|---|---|---|---|---|---|---|---|---|---|---|---|---|---|---|---|---|---|---|---|---|
| Localization | WT1 | WT2 | WT3 | RAP60 | RAP140 | RAP220 | RAP300 | RAP380 | RAP460 | RAP540 | RAP620 | RAP700 | HU80 | HU120 | HU160 | rpd3Δ_1 | rpd3Δ_2 | rpd3Δ_3 | WT1 | WT2 | WT3 | AF100 | AF140 | AF180 |
| Cortical Patches | 1 | 0 | 0 | 0 | 0 | 0 | 0 | 1 | 1 | 0 | 1 | 3 | 0 | 0 | 0 | 7 | 6 | 7 | 7 | 1 | 0 | 1 | 4 | 7 |
| Bud | 2 | 0 | 0 | 1 | 0 | 1 | 9 | 8 | 7 | 5 | 12 | 9 | 0 | 1 | 0 | 1 | 5 | 5 | 0 | 0 | 0 | 0 | 6 | 2 |
| Bud Neck | 0 | 0 | 0 | 2 | 3 | 1 | 3 | 13 | 8 | 10 | 1 | 3 | 3 | 1 | 4 | 4 | 2 | 1 | 2 | 2 | 0 | 0 | 2 | 6 |
| Bud Site | 0 | 0 | 0 | 0 | 0 | 0 | 0 | 1 | 1 | 1 | 1 | 1 | 0 | 0 | 0 | 0 | 0 | 0 | – | – | – | – | – | – |
| Cell Periphery | 0 | 0 | 0 | 1 | 3 | 4 | 1 | 1 | 1 | 1 | 1 | 0 | 1 | 3 | 3 | 10 | 7 | 10 | 0 | 0 | 0 | 2 | 6 | 7 |
| Cytoplasm | 179 | 102 | 16 | 160 | 261 | 238 | 382 | 353 | 196 | 311 | 215 | 218 | 266 | 370 | 463 | 277 | 271 | 227 | 117 | 86 | 36 | 150 | 251 | 307 |
| Endoplasmic Reticulum | 8 | 3 | 0 | 1 | 2 | 0 | 0 | 0 | 1 | 1 | 4 | 11 | 1 | 0 | 1 | 18 | 16 | 10 | 31 | 3 | 2 | 2 | 5 | 7 |
| Endosome | 0 | 1 | 0 | 0 | 1 | 0 | 2 | 1 | 1 | 5 | 1 | 0 | 0 | 1 | 0 | 6 | 8 | 10 | 6 | 2 | 0 | 1 | 4 | 7 |
| Golgi | 0 | 0 | 0 | 0 | 0 | 0 | 0 | 0 | 0 | 0 | 0 | 0 | 0 | 0 | 0 | 1 | 2 | 4 | 0 | 1 | 0 | 0 | 1 | 1 |
| Mitochondria | 32 | 3 | 1 | 4 | 0 | 25 | 78 | 49 | 96 | 89 | 169 | 101 | 1 | 1 | 2 | 4 | 5 | 5 | 53 | 13 | 5 | 23 | 29 | 40 |
| Nucleus | 0 | 0 | 0 | 2 | 2 | 1 | 1 | 2 | 1 | 0 | 2 | 1 | 0 | 0 | 0 | 0 | 2 | 0 | 0 | 0 | 0 | 0 | 1 | 0 |
| Nuclear Periphery | 0 | 1 | 0 | 0 | 0 | 0 | 2 | 0 | 0 | 0 | 0 | 0 | 0 | 0 | 0 | 1 | 0 | 0 | 0 | 0 | 0 | 0 | 0 | 0 |
| Nucleolus | 0 | 0 | 0 | 1 | 0 | 0 | 0 | 0 | 0 | 1 | 0 | 0 | 0 | 0 | 0 | 0 | 0 | 0 | 0 | 0 | 0 | 0 | 0 | 0 |
| Peroxisomes | 0 | 0 | 0 | 0 | 0 | 1 | 2 | 0 | 0 | 1 | 0 | 0 | 0 | 0 | 0 | 0 | 0 | 0 | 0 | 0 | 0 | 0 | 0 | 0 |
| SpindlePole | 0 | 0 | 0 | 0 | 1 | 2 | 4 | 7 | 2 | 7 | 4 | 3 | 0 | 0 | 0 | 1 | 2 | 2 | 1 | 0 | 0 | 1 | 3 | 6 |
| Vac/Vac Membrane | 2 | 1 | 0 | 3 | 1 | 4 | 2 | 2 | 3 | 8 | 3 | 5 | 0 | 1 | 3 | 6 | 8 | 6 | 11 | 7 | 2 | 3 | 7 | 13 |
| Unique Cell Count | 208 | 110 | 16 | 167 | 266 | 251 | 436 | 397 | 261 | 386 | 323 | 316 | 267 | 373 | 468 | 306 | 298 | 255 | 238 | 122 | 51 | 194 | 335 | 420 |
| Labelled Cell Count | 224 | 111 | 17 | 175 | 274 | 277 | 486 | 438 | 318 | 440 | 414 | 355 | 272 | 378 | 476 | 336 | 334 | 287 | 238 | 122 | 51 | 194 | 335 | 420 |
Yeast GFP Assignment
Protein Abundance
| Screen | WT1 | WT2 | WT3 | RAP60 | RAP140 | RAP220 | RAP300 | RAP380 | RAP460 | RAP540 | RAP620 | RAP700 | HU80 | HU120 | HU160 | rpd3Δ_1 | rpd3Δ_2 | rpd3Δ_3 | AF100 | AF140 | AF180 |
|---|---|---|---|---|---|---|---|---|---|---|---|---|---|---|---|---|---|---|---|---|---|
| Mean Cell GFP Intensity (1e-4) | 3.5 | 4.4 | 3.9 | 4.6 | 5.0 | 4.3 | 3.9 | 4.2 | 3.8 | 3.8 | 3.5 | 3.7 | 5.2 | 5.2 | 5.1 | 5.9 | 6.6 | 6.6 | 4.5 | 5.0 | 5.1 |
| Std Deviation (1e-4) | 0.4 | 0.7 | 0.6 | 1.3 | 1.3 | 1.3 | 1.2 | 0.9 | 1.6 | 1.1 | 1.0 | 0.7 | 1.2 | 0.9 | 1.4 | 1.0 | 1.6 | 1.8 | 0.7 | 1.6 | 1.4 |
| Intensity Change (Log2) | – | – | – | 0.21 | 0.34 | 0.13 | -0.01 | 0.08 | -0.06 | -0.05 | -0.19 | -0.1 | 0.39 | 0.4 | 0.38 | 0.59 | 0.73 | 0.74 | 0.18 | 0.33 | 0.38 |
Localization Change
| Localization | RAP60 | RAP140 | RAP220 | RAP300 | RAP380 | RAP460 | RAP540 | RAP620 | RAP700 | HU80 | HU120 | HU160 | rpd3Δ_1 | rpd3Δ_2 | rpd3Δ_3 |
|---|---|---|---|---|---|---|---|---|---|---|---|---|---|---|---|
| Actin | – | – | – | – | – | – | – | – | – | – | – | – | – | – | – |
| Bud | – | – | – | – | – | – | – | – | – | – | – | – | – | – | – |
| Bud Neck | – | – | – | – | – | – | – | – | – | – | – | – | – | – | – |
| Bud Site | – | – | – | – | – | – | – | – | – | – | – | – | – | – | – |
| Cell Periphery | – | – | – | – | – | – | – | – | – | – | – | – | – | – | – |
| Cyto | – | – | – | – | – | – | – | – | – | – | – | – | – | – | – |
| Endoplasmic Reticulum | – | – | – | – | – | – | – | – | – | – | – | – | – | – | – |
| Endosome | – | – | – | – | – | – | – | – | – | – | – | – | – | – | – |
| Golgi | – | – | – | – | – | – | – | – | – | – | – | – | – | – | – |
| Mitochondria | – | – | – | – | – | – | – | – | – | – | – | – | – | – | – |
| Nuclear Periphery | – | – | – | – | – | – | – | – | – | – | – | – | – | – | – |
| Nuc | – | – | – | – | – | – | – | – | – | – | – | – | – | – | – |
| Nucleolus | – | – | – | – | – | – | – | – | – | – | – | – | – | – | – |
| Peroxisomes | – | – | – | – | – | – | – | – | – | – | – | – | – | – | – |
| SpindlePole | – | – | – | – | – | – | – | – | – | – | – | – | – | – | – |
| Vac | – | – | – | – | – | – | – | – | – | – | – | – | – | – | – |
| Cortical Patches | – | – | – | – | – | – | – | – | – | – | – | – | – | – | – |
| Cytoplasm | – | – | – | – | – | – | – | – | – | – | – | – | – | – | – |
| Nucleus | – | – | – | – | – | – | – | – | – | – | – | – | – | – | – |
| Vacuole | – | – | – | – | – | – | – | – | – | – | – | – | – | – | – |
External localization resources
Images






























Protein Concentration and Protein Localization Data
| R1 | R2 | R3 | ||||||||||||||||
|---|---|---|---|---|---|---|---|---|---|---|---|---|---|---|---|---|---|---|
| G1 Pre-START | G1 Post-START | S/G2 | Metaphase | Anaphase | Telophase | G1 Pre-START | G1 Post-START | S/G2 | Metaphase | Anaphase | Telophase | G1 Pre-START | G1 Post-START | S/G2 | Metaphase | Anaphase | Telophase | |
| Concentration | 1.767 | 1.6526 | 1.5782 | -0.8178 | 0.1373 | 0.0883 | -0.4169 | 0.1092 | -0.1568 | -0.3699 | -0.2963 | -0.1442 | -1.1532 | -1.0282 | -1.0649 | -1.0211 | -0.705 | -1.1292 |
| Actin | 0.0198 | 0.0018 | 0.0134 | 0.0023 | 0.0256 | 0.0035 | 0.0167 | 0.001 | 0.0047 | 0.0066 | 0.0178 | 0.003 | 0.0232 | 0.001 | 0.0127 | 0.0042 | 0.0476 | 0.004 |
| Bud | 0.0013 | 0.0035 | 0.0057 | 0.0002 | 0.0038 | 0.001 | 0.0004 | 0.0025 | 0.0011 | 0.0002 | 0.0004 | 0.0002 | 0.0014 | 0.0074 | 0.0008 | 0.0003 | 0.0007 | 0.0015 |
| Bud Neck | 0.0012 | 0.0003 | 0.0007 | 0.0002 | 0.0011 | 0.0015 | 0.0074 | 0.0007 | 0.0018 | 0.0004 | 0.0009 | 0.0005 | 0.0018 | 0.0042 | 0.0005 | 0.0002 | 0.0005 | 0.0023 |
| Bud Periphery | 0.0008 | 0.0036 | 0.0083 | 0.0003 | 0.0069 | 0.0008 | 0.0007 | 0.0011 | 0.002 | 0.0003 | 0.0006 | 0.0003 | 0.0024 | 0.0039 | 0.0022 | 0.0004 | 0.0007 | 0.0011 |
| Bud Site | 0.0084 | 0.0192 | 0.0113 | 0.0002 | 0.0241 | 0.0043 | 0.0099 | 0.0136 | 0.012 | 0.0012 | 0.0014 | 0.0001 | 0.0083 | 0.0203 | 0.0053 | 0.0006 | 0.0019 | 0.0004 |
| Cell Periphery | 0.0007 | 0.0006 | 0.0005 | 0.0001 | 0.0005 | 0.0001 | 0.0005 | 0.0002 | 0.0003 | 0.0002 | 0.0001 | 0.0001 | 0.0007 | 0.0004 | 0.0004 | 0.0001 | 0.0001 | 0.0001 |
| Cytoplasm | 0.0985 | 0.1239 | 0.1125 | 0.1978 | 0.0604 | 0.1747 | 0.1072 | 0.1381 | 0.1539 | 0.0847 | 0.1398 | 0.2176 | 0.1534 | 0.2697 | 0.2422 | 0.1655 | 0.0882 | 0.3255 |
| Cytoplasmic Foci | 0.0345 | 0.0132 | 0.0273 | 0.0161 | 0.0296 | 0.0285 | 0.0296 | 0.0074 | 0.0202 | 0.0265 | 0.0619 | 0.008 | 0.0213 | 0.0135 | 0.0253 | 0.0206 | 0.0877 | 0.0274 |
| Eisosomes | 0.0004 | 0.0004 | 0.0004 | 0.0001 | 0.0005 | 0.0002 | 0.0003 | 0.0001 | 0.0002 | 0.0002 | 0.0011 | 0.0001 | 0.0004 | 0.0004 | 0.0005 | 0.0002 | 0.0001 | 0.0001 |
| Endoplasmic Reticulum | 0.0075 | 0.0038 | 0.0049 | 0.0045 | 0.0041 | 0.0058 | 0.0074 | 0.0039 | 0.0044 | 0.0012 | 0.0018 | 0.0054 | 0.0097 | 0.011 | 0.0115 | 0.0051 | 0.0009 | 0.0125 |
| Endosome | 0.0494 | 0.0059 | 0.0204 | 0.0173 | 0.1251 | 0.01 | 0.0159 | 0.0026 | 0.0173 | 0.0279 | 0.0124 | 0.005 | 0.0187 | 0.007 | 0.0221 | 0.0199 | 0.0322 | 0.0083 |
| Golgi | 0.0098 | 0.0004 | 0.0096 | 0.0077 | 0.0377 | 0.0014 | 0.0048 | 0.0002 | 0.0013 | 0.0087 | 0.01 | 0.0012 | 0.0078 | 0.0005 | 0.0079 | 0.0013 | 0.0247 | 0.0056 |
| Lipid Particles | 0.0237 | 0.002 | 0.0226 | 0.0074 | 0.0513 | 0.0036 | 0.0107 | 0.0007 | 0.006 | 0.0647 | 0.023 | 0.0052 | 0.0121 | 0.0017 | 0.01 | 0.0037 | 0.0596 | 0.0078 |
| Mitochondria | 0.0227 | 0.023 | 0.0332 | 0.0331 | 0.0279 | 0.0079 | 0.0039 | 0.0007 | 0.0014 | 0.0063 | 0.0055 | 0.0009 | 0.0199 | 0.0009 | 0.023 | 0.0013 | 0.0044 | 0.0147 |
| None | 0.647 | 0.7859 | 0.6999 | 0.7022 | 0.5368 | 0.7302 | 0.7315 | 0.812 | 0.7519 | 0.7346 | 0.6642 | 0.7417 | 0.6922 | 0.6479 | 0.611 | 0.7543 | 0.5758 | 0.5703 |
| Nuclear Periphery | 0.0182 | 0.0027 | 0.0035 | 0.0018 | 0.0236 | 0.0068 | 0.0125 | 0.0015 | 0.0022 | 0.002 | 0.0102 | 0.0016 | 0.0045 | 0.0033 | 0.0048 | 0.0083 | 0.0007 | 0.0028 |
| Nucleolus | 0.0047 | 0.0009 | 0.0009 | 0.0002 | 0.0012 | 0.001 | 0.0038 | 0.0007 | 0.0012 | 0.0008 | 0.0029 | 0.0002 | 0.0009 | 0.0002 | 0.0007 | 0.0007 | 0.0001 | 0.0003 |
| Nucleus | 0.0083 | 0.0034 | 0.0017 | 0.0012 | 0.004 | 0.002 | 0.0048 | 0.0043 | 0.0025 | 0.0016 | 0.0033 | 0.0016 | 0.0019 | 0.0021 | 0.0021 | 0.003 | 0.0002 | 0.0019 |
| Peroxisomes | 0.0177 | 0.0008 | 0.0166 | 0.0036 | 0.017 | 0.0086 | 0.0139 | 0.0003 | 0.0052 | 0.0217 | 0.024 | 0.004 | 0.0105 | 0.0006 | 0.008 | 0.001 | 0.0664 | 0.0094 |
| Punctate Nuclear | 0.0079 | 0.0017 | 0.0027 | 0.0012 | 0.0061 | 0.0063 | 0.0139 | 0.0072 | 0.0072 | 0.0045 | 0.0172 | 0.0024 | 0.0043 | 0.0011 | 0.004 | 0.0045 | 0.0064 | 0.0022 |
| Vacuole | 0.0135 | 0.002 | 0.0028 | 0.0016 | 0.0082 | 0.0012 | 0.0024 | 0.001 | 0.0028 | 0.004 | 0.0005 | 0.0009 | 0.0036 | 0.0025 | 0.004 | 0.0035 | 0.0008 | 0.0012 |
| Vacuole Periphery | 0.0042 | 0.001 | 0.0011 | 0.0007 | 0.0045 | 0.0004 | 0.0015 | 0.0001 | 0.0005 | 0.0018 | 0.0008 | 0.0002 | 0.0009 | 0.0004 | 0.0011 | 0.0012 | 0.0004 | 0.0004 |
Sequencing Data
| R1 | R2 | |||||||||
|---|---|---|---|---|---|---|---|---|---|---|
| G1 Post-START | S/G2 | Metaphase | Anaphase | Telophase | G1 Post-START | S/G2 | Metaphase | Anaphase | Telophase | |
| Gene Expression | 31.34 | 31.7163 | 29.8108 | 41.7562 | 34.5003 | 34.2776 | 45.4301 | 48.3381 | 50.2759 | 44.0126 |
| Translational Efficiency | 1.6355 | 1.4587 | 1.8596 | 1.5993 | 1.4211 | 1.9144 | 1.3115 | 1.2272 | 1.4937 | 1.2159 |
Hit Data
| Dataset | Hit |
|---|---|
| Protein Concentration | ✘ |
| Protein Localization | ✘ |
| Gene Expression | ✔ |
| Translational Efficiency | ✘ |
Endocytosis
| Temp | Actin Patch (Sac6-tdTomato) | Cortical Patch (Sla1-GFP) | Late Endosome (Snf7-GFP) | Vacuole (Vph1-GFP) |
|---|---|---|---|---|
| 37℃ | ||||
| RT |
Cell Cycle Omics
CYCLoPs (Yip5-GFP)
| Gene / Allele | Actin Patch (Sac6-tdTomato) | Cortical Patch (Sla1-GFP) | Late Endosome (Snf7-GFP) | Vacuole (Sac6-tdTomato) |
|---|
| Gene | Images |
|---|
| Gene | Images |
|---|
Images are not yet available
Images are not yet available